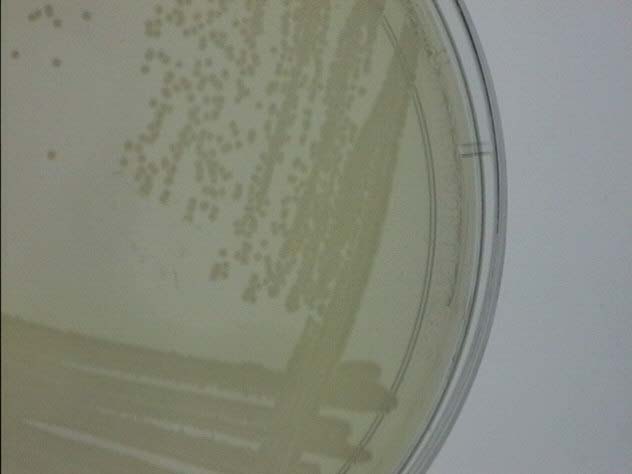

| Pseudomonas colonies on Isolation Plates | |
Small, beige, round, and smooth colonies. One plate shows transparent green pigment. |
| Pseudomonas colonies on Oil Plates |  |
No growth |
| Gram Stain |  |
Stained pink cells |
| Wet Mount/ Motility |  |
Motile |
| Catalase Test |  |
Emission of bubbles |
| Oxidase Test |  |
Turned blue after 5 minutes |